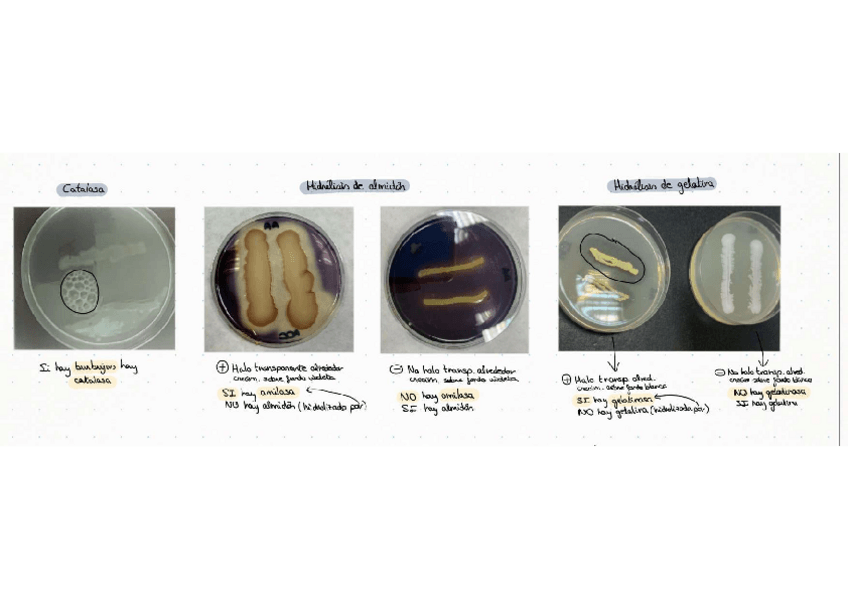

@farmaamj
146 Publicaciones
4.62k Interacciones
4 Seguidores
0 Siguiendo
Lista de publicaciones de farmaamj
He publicado nuevos practicas de 2º Microbiología: Pruebas-bioquimicas.pdf
apuntes
-
Temario
He publicado nuevos apuntes de 2º Quimioinformática, Investigación e Historia de la Farmacia: Temario
practicas
-
Apuntes examen prácticas TF 1
He publicado nuevos practicas de 3º Tecnología Farmacéutica I: Apuntes examen prácticas TF 1
He publicado nuevos apuntes de 2º Fundamentos Fisicoquímicos de las Técnicas Instrumentales: Tema-2-Fundamentos.pdf
He publicado nuevos apuntes de 2º Fundamentos Fisicoquímicos de las Técnicas Instrumentales: Tema-1-Fundamentos.pdf
He publicado nuevos ejercicios de 2º Química Analítica Aplicada: Seminarios-resueltos.pdf
He publicado nuevos apuntes de 2º Química Analítica Aplicada: Resumen-teoria-seminarios.pdf
He publicado nuevos apuntes de 2º Química Analítica Aplicada: Apuntes-seminarios.pdf
He publicado nuevos apuntes de 2º Química Analítica Aplicada: Apuntes-examen.pdf
apuntes
-
Teoría analítica
He publicado nuevos apuntes de 2º Química Analítica Aplicada: Teoría analítica